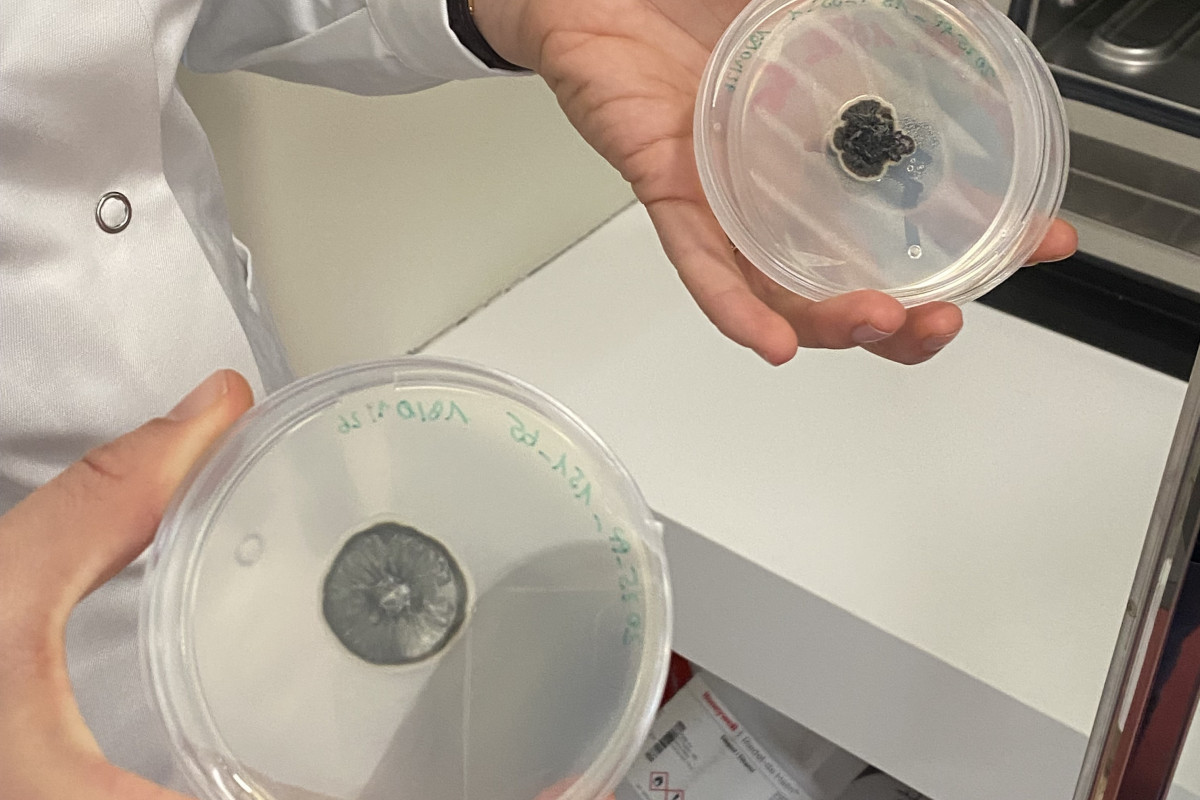

Forschung braucht Frauen

-
Heute, am 11. Februar, begehen wir den Internationalen Tag der Frauen und Mädchen in der Forschung. Ein Tag, der nicht nur wissenschaftliche Exzellenz feiert, sondern auch die Barrieren beleuchtet, die Frauen auf ihrem Karriereweg noch immer überwinden müssen. In dieser Folge von „SALTO unterwegs“ gibt uns Stefanie Primisser passend dazu einen tiefen Einblick in ihren Alltag als Phytopathologin am Versuchszentrum Laimburg.
-
Unterwegs
Diese Podcastreihe stellt interessante Menschen und ihre Geschichten in den Mittelpunkt. Wir treffen uns mit Menschen aus verschiedenen Bereichen wie Kultur, Wissenschaft, Landwirtschaft, Psychologie und vielen mehr, um über ihre Arbeit, ihre Leidenschaften und ihre Erfahrungen zu sprechen. Die Gespräche finden vor Ort statt, wo die Gäste ihre Arbeit machen oder ihre Freizeit verbringen.
-
Als Expertin für Pflanzenkrankheiten erforscht die gebürtige Vinschgerin Erreger, die unsere heimische Landwirtschaft bedrohen. Doch das Gespräch dreht sich nicht nur um Laborergebnisse, sondern vor allem um die Realität hinter der Forschung: Stefanie Primisser blickt auf ihren Werdegang von Wien zurück nach Südtirol und räumt mit romantischen Vorstellungen vom Forscherdasein auf. Einen Platz in der Wissenschaft zu finden ist schwer – ihn dauerhaft zu halten, oft noch schwerer. Familiäre Pausen können schnell das berufliche Aus bedeuten.
Dass es auch anders geht, beweist die Laimburg: Mit einer Frauenquote von rund 50 % gilt die Institution als lokales Vorbild für paritätische Teams.
Dennoch bleibt der Blick über die Landesgrenzen hinweg kritisch. Während Stefanie Primisser aus ihrer Zeit in Österreich gezielte Programme zur Nachwuchsförderung (wie die FFG-Praktika) kennt, die Studentinnen den Weg in die angewandte Forschung ebnen, sucht man solche zentralen Einstiegshilfen in Italien oft vergeblich. Ein Gespräch über die Leidenschaft für die Wissenschaft und den langen Atem, den es braucht, um in einem starren System nicht „weg vom Fenster“ zu sein.
Zur Folge
Verfügbar auf:
Spotify ● Apple Podcasts ● Youtube ● Castbox ● Amazon Music ● Audible ● Spreaker
Gesamte Serie:Versuchszentrum LaimburgForschungsschwerpunkt: Als führende Forschungsinstitution für die Landwirtschaft in Südtirol betreibt die Laimburg angewandte Forschung in den Bereichen Obst-, Wein- und Berglandwirtschaft sowie in der Lebensmittelwissenschaft und im Pflanzenschutz.
Wissenschaftliche Tätigkeit: Im aktuellen Tätigkeitsprogramm 2026 werden insgesamt 441 Forschungsprojekte und -tätigkeiten abgewickelt. Ein Schwerpunkt liegt auf der Phytopathologie zur Identifizierung und Bekämpfung von Krankheitserregern (Pilze, Bakterien, Viren)
Netzwerk: Die Laimburg kooperiert international mit Universitäten und Forschungszentren, dient aber primär als wissenschaftlicher Partner für die lokale Praxis.
Weitere Artikel zum Thema
Gesellschaft | UnterwegsEinsatz zwischen Rotor & Gipfel
Gesellschaft | Unterwegs2026: Der große Kurswechsel
Gesellschaft | UnterwegsAufbruch statt Tabu

Stimme zu, um die Kommentare zu lesen - oder auch selbst zu kommentieren. Du kannst Deine Zustimmung jederzeit wieder zurücknehmen.